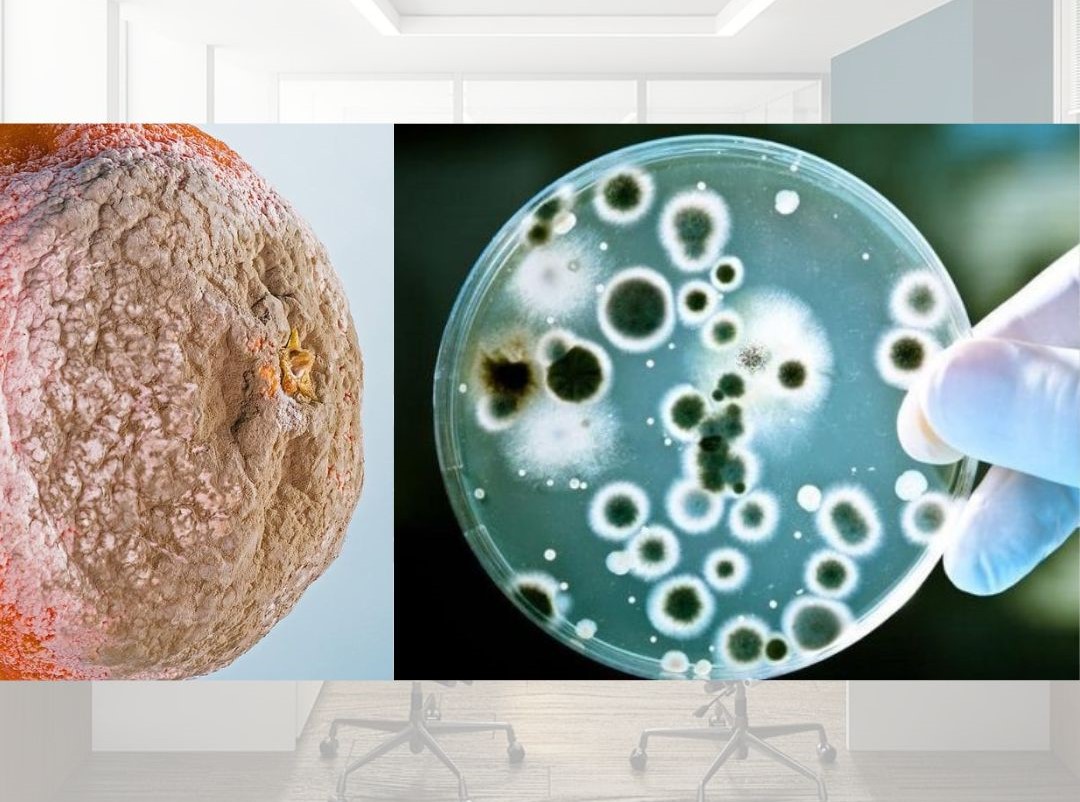

Monitoreos Ocupacionales
Agentes Físicos

Monitoreo de ILUMINACIÓN
RM–375-2008-TR: TITULO VII - CONDICIONES AMBIENTALES DE TRABAJO En todos los lugares de trabajo debe haber una iluminación homogénea y bien distribuida, sea del tipo natural o artificial o localizada, de acuerdo a la naturaleza de la actividad, de tal forma que no sea un factor de riesgo para la salud de los trabajadores al realizar sus actividades.

Monitoreo de ESTRÉS TÉRMICO
Incluye estrés por calor, frio y confort térmico. Realizamos las evaluaciones usando el estándar ISO 7243:2017 “Estimación del estrés térmico del hombre en el trabajo basado en el índice TGBH” e ISO 8996: 2004 Determinación de la tasa METABOLICA

Monitoreo de VIBRACIONES
Realizamos monitoreos de: Cuerpo entero ISO 2631: Evaluación de la exposición humana a las vibraciones de cuerpo entero. Mano brazo ISO 5349 Medición y evaluación de la exposición humana a las vibraciones transmitidas por la mano.

Monitoreo de RUIDO
Realizamos monitoreos de RUIDO teniendo en cuenta estrictamente lo establecido en la NTP ISO 9612 Revisión 2020.
Agentes Químicos

Monitoreo de HUMOS METALICOS
Se realizan las tomas de muestra según metodologías NIOSH 7300, 7301, 7303; como análisis multielemental simultáneo sin realizar un análisis por cada contaminante. Cuyos LMP los encontramos de manera especifica en el DS N° 015 2005 SA.

Monitoreo de Partículas RESPIRABLES
Realizamos el monitoreo de partículas respirables, según método NIOSH 0600, ejecutamos la calibración de flujo in-situ, según método.

Monitoreo de partículas INHALABLES
Realizamos el monitoreo de partículas inhalables, según método NIOSH 0500, ejecutamos la calibración de flujo in-situ, según método.

Monitoreo de Compuestos Orgánicos Volátiles (COVs)
Se realizan dos tipos de monitoreos:
- El primero, mediante el uso de un sistema en línea con tubos de carbón activado y flujo de aire, luego los tubos son enviados a laboratorios EXTRANJEROS.
- El segundo modo se realiza mediante lectura directa, sin embargo este método está sujeto a interpretaciones técnicas de las personas.

Monitoreo de ASBESTO y OTRAS FIBRAS
Realizamos el muestreo de ASBESTO y OTRAS FIBRAS utilizando el método NIOSH 7400.
En el caso del ASBESTO tenemos los LMP en el DS 015 2005 SA, como amianto.
Con esta metodología podemos realizar evaluaciones de FIBRAS MINERALES artificiales y fibras de PAPEL y ALGODON.

Monitoreo de SILICE CRISTALINA
Muestreo mediante NIOSH 7602 Determinación de SÍLICE CRISTALINA por espectrofotometría de absorción infrarroja.
También podemos determinar la SILICE mediante otros métodos NIOSH similares.
Agentes Biológicos

Calidad de AIRE INTERIOR
Ejecución según el método NIOSH 0800 Usando un impactador de cascada “Andersen” y bomba de muestreo calibrada a 28.3 l/min para captación del aire interior (Oficina, aire acondicionado)
Monitoreo de HONGOS
Por ejemplo Mohos y Levaduras.
Los MOHOS crecen en condiciones cálidas y húmedas, su propagación y reproducción se realiza mediante esporas.
La importancia de los HONGOS en la higiene industrial radica, que existen algunos que pueden generar enfermedades (Por ejemplo: Aspergiloma Pulmonar, Histoplasmosis entre otros.)

Monitoreo de COLIFORMES
Las bacterias coliformes no deben estar presentes en sistemas de abastecimiento, almacenamiento y distribución de agua y, si así ocurriese, es indicio de que el tratamiento fue inadecuado o que se produjo contaminación posterior
Los coliformes fecales mayoritariamente comprenden el género Escherichia. Son responsables de gastroenteritis, la infección puede ser adquirida por el consumo de alimentos tales como vegetales frescos y agua.

CASOS DE OTROS AGENTES BIOLOGICOS
Es importante conocer que cada empresa y cada actividad conlleva sus propios riesgos biológicos, en ese sentido es crucial realizar el análisis exhaustivo de RIESGOS para poder identificar los agentes biológicos presentes; para ello tenemos una herramienta muy importante como la RM N° 480 2008 MINSA.
Agentes de Riesgos Psicosociales
Realizamos monitoreos de riesgos psicosociales haciendo uso de las herramientas más reconocidas a nivel global, como la CoPSoQ-ISTAS 21, en sus dos versiones; versión corta (Empresas con menos de 25 trabajadores) y versión media (Empresas de 25 a más trabajadores).
Del mismo modo realizamos la evaluación mediante el método CENSOPAS-CoPSoQ, versión del ISTAS 21 validado para la realidad peruana.
Agentes Disergonómicos

Levantamiento manual de cargas
La evaluación se realiza mediante la Ecuación de NIOSH en las tareas que se realizan levantamientos de carga.
El resultado de la aplicación de la ecuación es el Peso Máximo Recomendado (RWL: Recommended Weight Limit) que se define como el peso máximo que es recomendable levantar en las condiciones del puesto para evitar el riesgo de lumbalgias o problemas de espalda.
Del mismo modo se aplica la metodología de evaluación ISO 11228-1 Manipulación y transporte parte 1.

Transporte de Cargas
Evaluación según la metodología ISO 11228-1 Manipulación y transporte parte 1.
Tablas de SNOOK y CIRIELLO que nos permiten determinar los pesos máximos aceptables para diferentes acciones en este caso Transporte de Cargas.

Empuje - Tracción de cargas
Evaluación según la metodología ISO 11228-2 Empuje y Tracción-parte 2.
Es importante mencionar que para realizar este tipo de evaluación NECESARIAMENTE debemos medir la fuerza inicial y la fuerza sostenida, debemos hacer uso de un DINAMOMETRO calibrado y con los rangos de medición acorde a tus actividades.

Movimientos Repetitivos
Evaluación según la metodología ISO 11228-3 Movimientos repetitivos de extremidades superiores.
Adicionalmente se pueden usar otras metodologías como OCRA Check List y JSI.

Posturas Forzadas
Evaluación según la metodología ISO 11226 Evaluación de Posturas Estáticas de Trabajo.
Adicionalmente se pueden usar otras metodologías como RULA, REBA, OWAS, etc.
